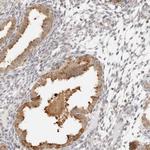
GORAB Antibody in Immunohistochemistry (Paraffin) (IHC (P))

Search
Invitrogen
GORAB Polyclonal Antibody
{{$productOrderCtrl.translations['antibody.pdp.commerceCard.promotion.promotions']}}
{{$productOrderCtrl.translations['antibody.pdp.commerceCard.promotion.viewpromo']}}
{{$productOrderCtrl.translations['antibody.pdp.commerceCard.promotion.promocode']}}: {{promo.promoCode}} {{promo.promoTitle}} {{promo.promoDescription}}. {{$productOrderCtrl.translations['antibody.pdp.commerceCard.promotion.learnmore']}}
产品信息
PA5-55557
种属反应
宿主/亚型
分类
类型
抗原
偶联物
形式
浓度
规格
纯化类型
保存液
内含物
保存条件
运输条件
RRID
产品详细信息
Immunogen sequence: FSSPTLPSHF TLTSPVGDGQ PQGIESQPKE LGLENSHDGH NNVEILPPKP DCKLEKKKVE LQEKSRWEVL QQEQRLME
Highest antigen sequence identity to the following orthologs: Mouse - 68%, Rat - 71%.
靶标信息
TCEB1 is known as protein elongin C, which is a subunit of the transcription factor B (SIII) complex. The SIII complex is composed of elongins A/A2, B and C. It activates elongation by RNA polymerase II by suppressing transient pausing of the polymerase at many sites within transcription units. Elongin A functions as the transcriptionally active component of the SIII complex, whereas elongins B and C are regulatory subunits. Elongin A2 is specifically expressed in the testis, and capable of forming a stable complex with elongins B and C. The von Hippel-Lindau tumor suppressor protein binds to elongins B and C, and thereby inhibits transcription elongation. Western blots using two different antibodies (P100962-T200 and P100963_P050 / P100963_P100) against two unique regions of this protein target confirm the same apparent molecular weight in our tests.
仅用于科研。不用于诊断过程。未经明确授权不得转售。
篇参考文献 (0)
生物信息学
蛋白别名: N-terminal kinase-like-binding protein 1; NTKL-binding protein 1; NTKL-BP1; RAB6-interacting golgin; SCY1-like 1-binding protein 1; SCYL1-binding protein 1; SCYL1-BP1; unnamed protein product
基因别名: GO; GORAB; NTKLBP1; SCYL1BP1
UniProt ID: (Human) Q5T7V8
Entrez Gene ID: (Human) 92344